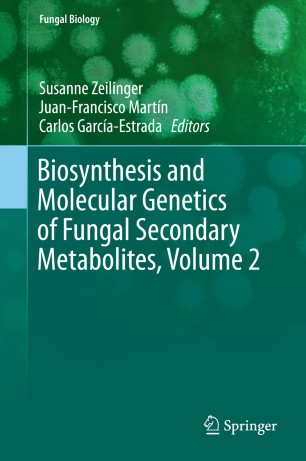

[PDF] The Biosynthesis Of Secondary Metabolites Ebook
Biosynthesis And Molecular Genetics Of Fungal Secondary
Biosynthesis and function of secondary metabolites This Thematic Series on the biosynthesis and function of secondary metabolites deals with the discovery of new biologically active compounds from all kinds of sources, including plants, bacteria, and fungi, and also with their biogenesis. KEGG PATHWAY: Biosynthesis of secondary metabolites ... M00113 Jasmonic acid biosynthesis Amino acid metabolism Serine and threonine metabolism M00018 Threonine biosynthesis, aspartate => homoserine => threonine Cysteine and methionine metabolism M00021 Cysteine biosynthesis, serine => cysteine M00368 Ethylene biosynthesis, methionine => ethylene; Branched-chain amino acid metabolism Plant secondary metabolism - Wikipedia Secondary metabolism produces a large number of specialized compounds (estimated 200,000) that do not aid in the growth and development of plants but are required for the plant to survive in its environment.Secondary metabolism is connected to primary metabolism by using building blocks and biosynthetic enzymes derived from primary metabolism. Primary metabolism governs all basic physiological ...

Biosynthesis And Molecular Genetics Of Fungal Secondary
Biosynthesis And Classification Of Secondary Metabolites
Bol Com Secondary Metabolite Biosynthesis And Metabolism

Molecules Free Full Text Tilting Plant Metabolism For

0 Response to "The Biosynthesis Of Secondary Metabolites"
Post a Comment